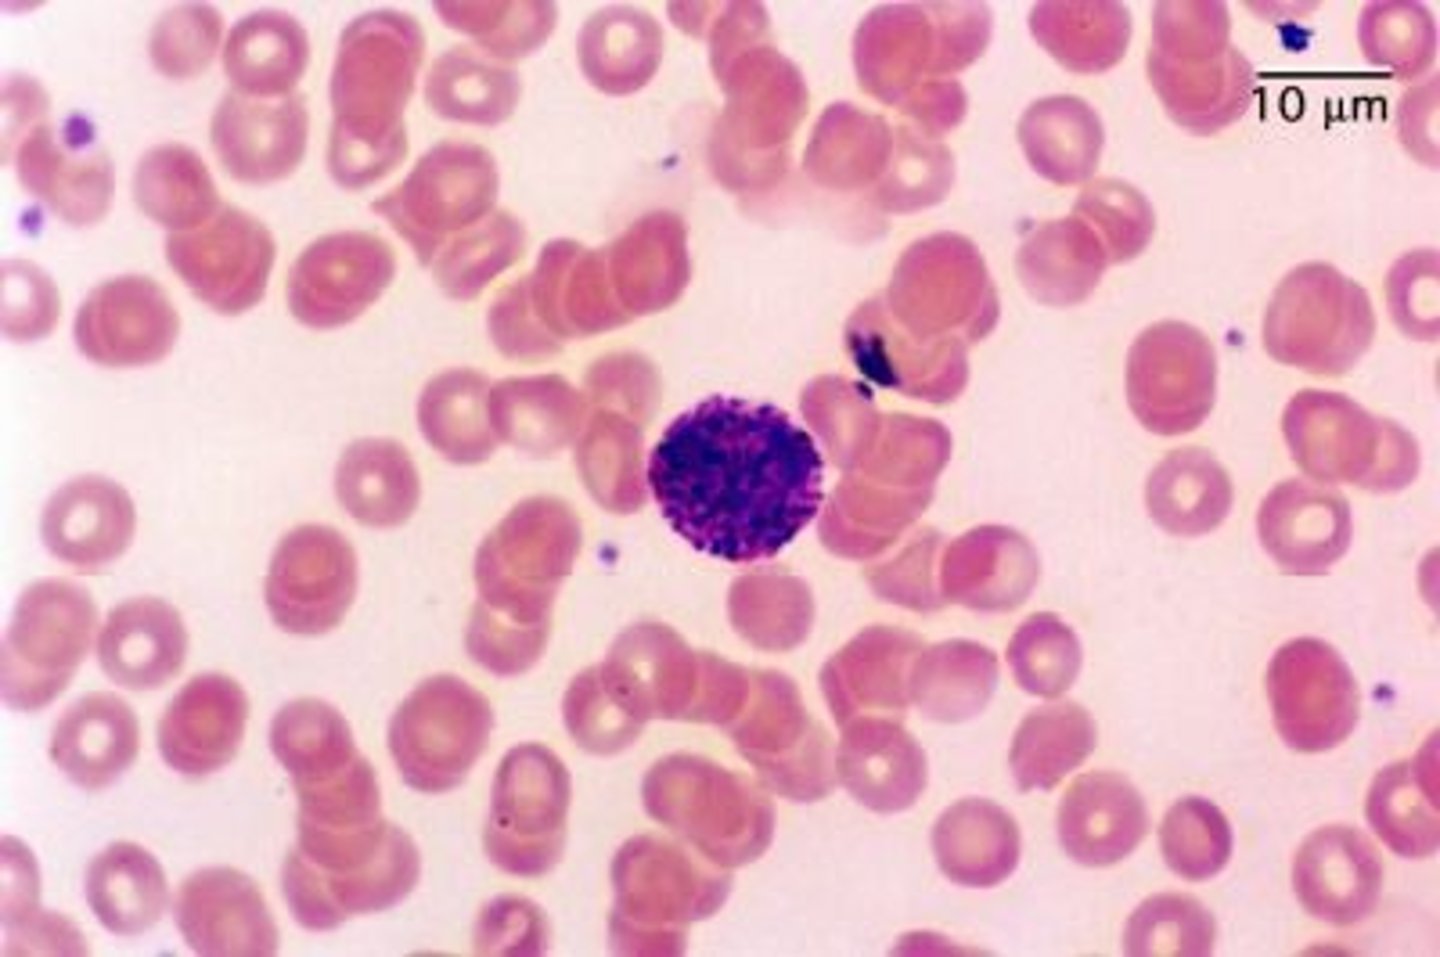
knowt flashcard image
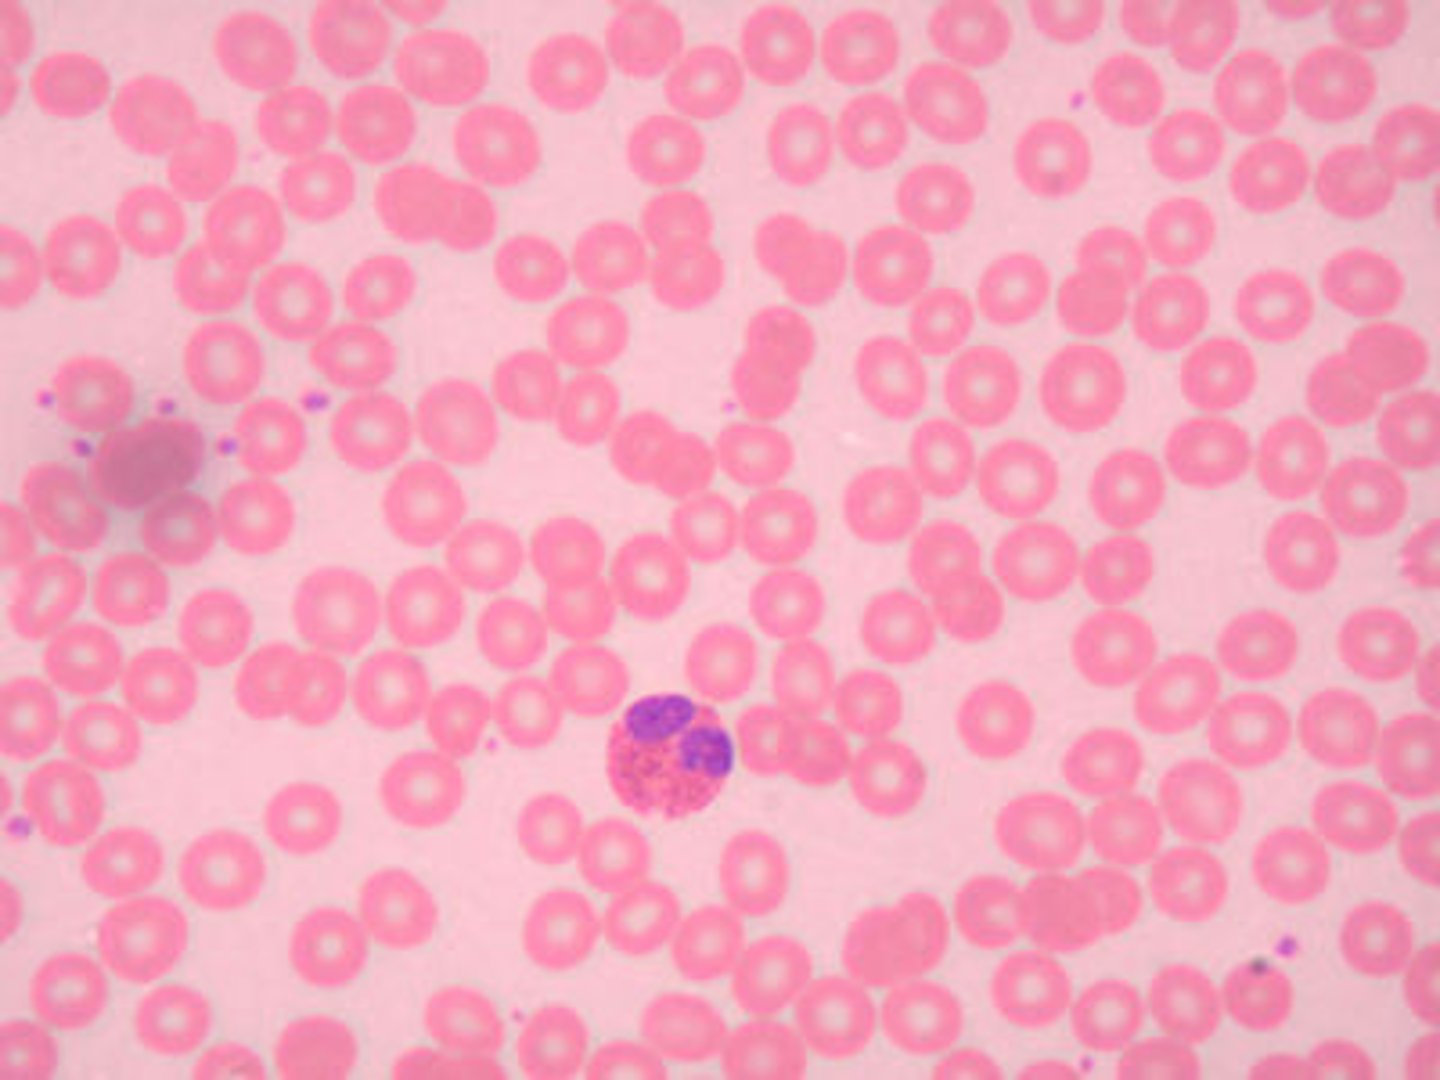
knowt flashcard image
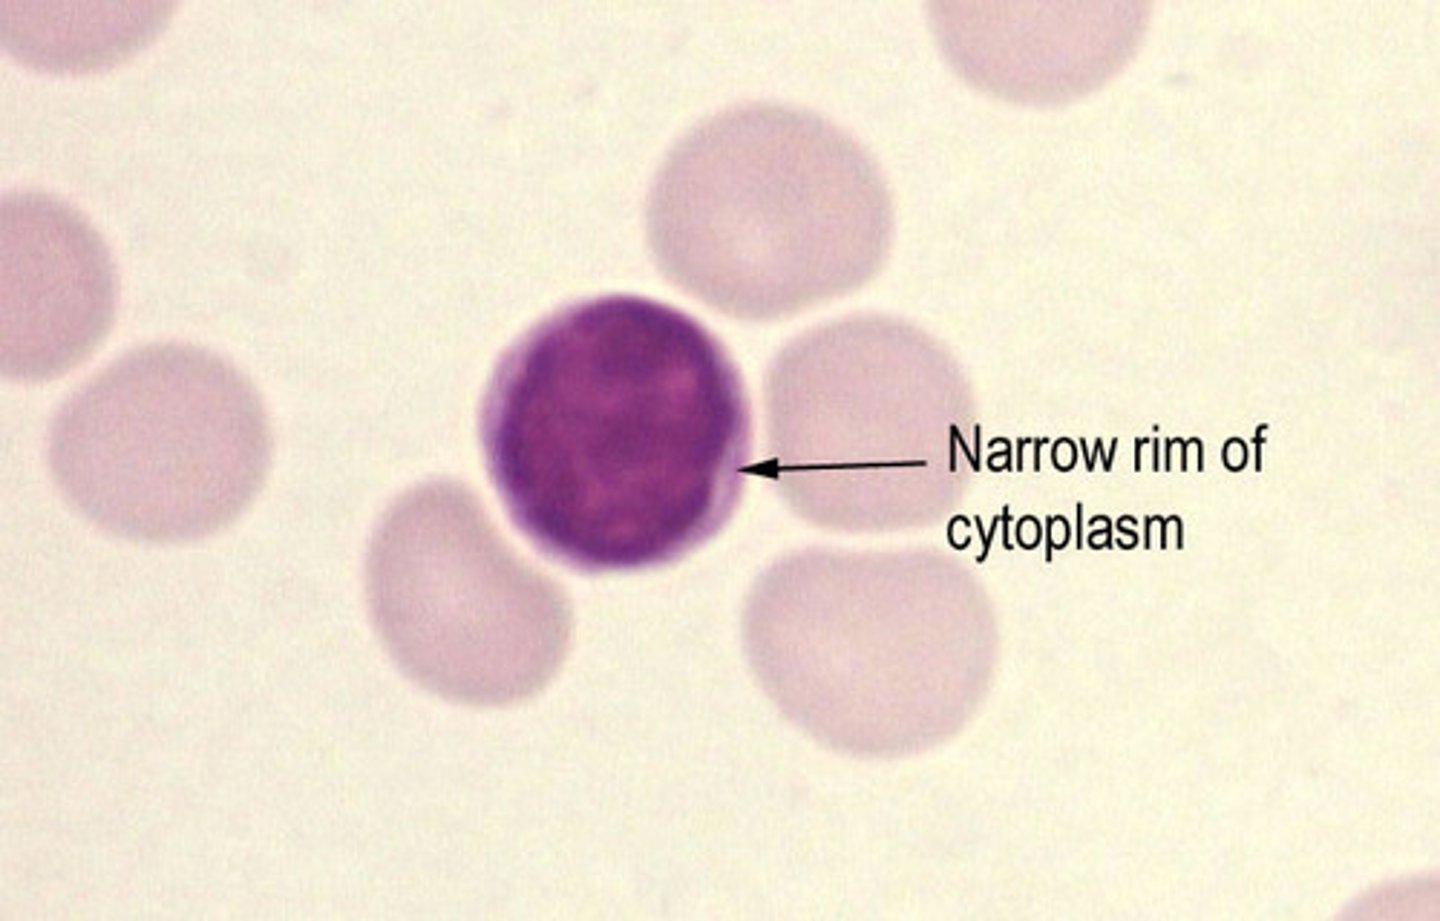
knowt flashcard image
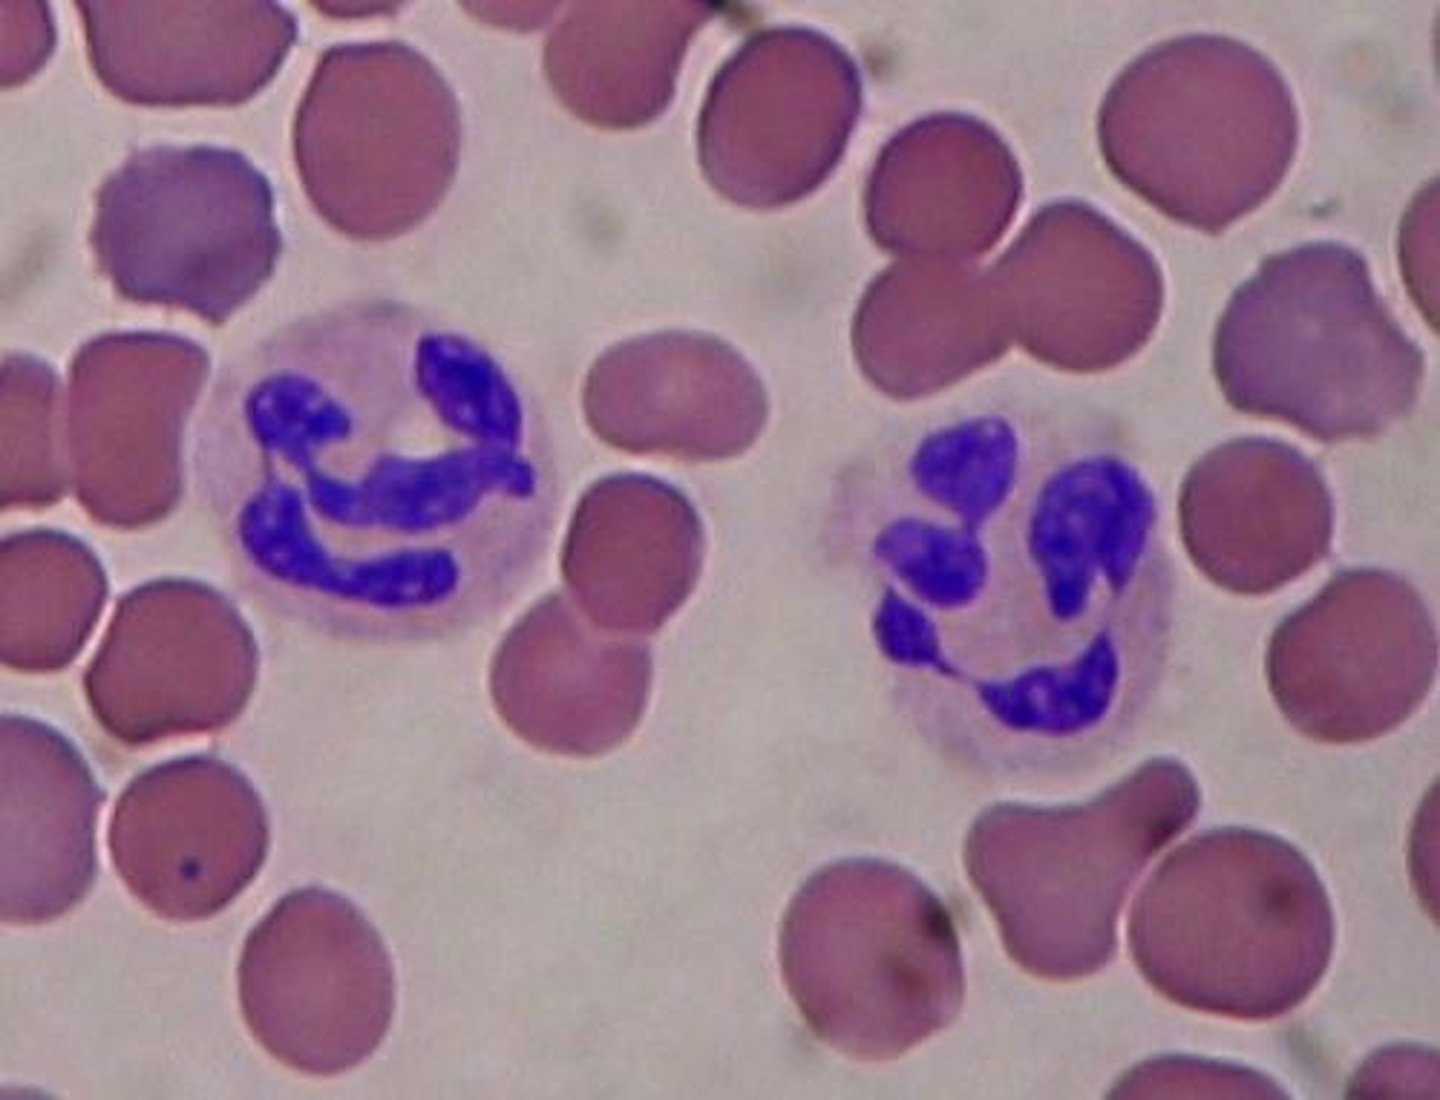
knowt flashcard image

1/7
Looks like no tags are added yet.
Name | Mastery | Learn | Test | Matching | Spaced | Call with Kai |
|---|
No analytics yet
Send a link to your students to track their progress
Basophils
Eosinophil
Lymphocyte
Monocyte

Neutrophils
Platelets

Red Blood Cells

see* Blood Vessel Layers
